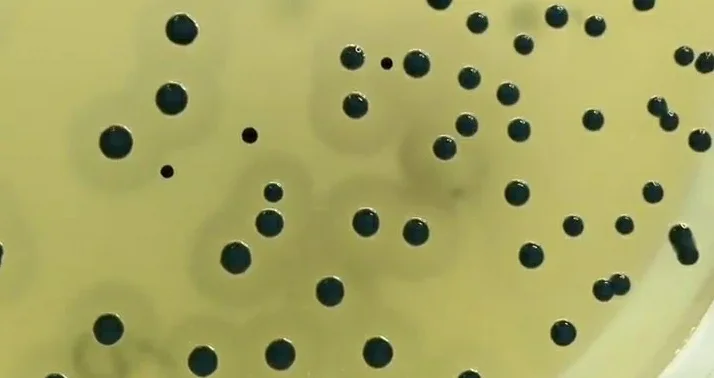
نتایج برد پارکر آگار

ابزار و وسایل آزمایشگاهی شامل، محلول ها کیت ها,ویکی ژن
برد پارکر آگار (Baird Parker Agar): ترکیب، اصول،آمادهسازی، نتایج و کاربرد
مقدمهای بر برد پارکر آگار
برد پارکر آگار توسط Baird Parker با استفاده از فرمولاسیون تلوریت-گلیسین (Tellurite-glycine) ابداع شده توسط Zebovitz و همکاران، برای جداسازی و شمارش استافیلوکوکها (Staphylococci) در غذا و سایر مواد ساخته شده است و امکان افتراق خوب سویههای کواگولاز (Coagulase) مثبت را فراهم میکند.
به این محیط، سدیم پیروات (Sodium pyruvate) به عنوان محرک رشد انتخابی و امولسیون زرده تخم مرغ به عنوان عامل افتراق اضافه شد. این محیط باعث رشد استافیلوکوکوس اورئوس (Staphylococcus aureus) میشود و به طور انتخابی از رشد بیشتر باکتریهای دیگر جلوگیری میکند.
بنابراین به عنوان یک محیط انتخابی و تشخیصی برای جداسازی و شمارش استافیلوکوکهای کواگولاز مثبت در غذاها در نظر گرفته میشود.
ترکیبات برد پارکر آگار
| عناصر | گرم در لیتر |
| تریپتون | 10 |
| HM Peptone B# | 5 |
| عصاره مخمر | 1 |
| گلیسین (Glycine) | 12 |
| پوروات سدیم (Sodium puruvate) | 10 |
| لیتیوم کلرید (Lithium chloride) | 5 |
| آگار | 20 |
pH نهایی (در 25 درجه سانتیگراد): 0.2±7.0
اصول برد پارکر آگار
- همبستگی بالایی بین تست کواگولاز و وجود ناحیه شفاف مربوط به فرایند لیپولیز (lipolysis) در این محیط یافت شده که این امر به دلیل فعالیت لسیتیناز (Lecithinase) مربوط به استافیلوکوک است که زرده تخم مرغ را تجزیه میکند.
- تقریباً 100٪ استافیلوکوکهای کواگولاز مثبت قادر به کاهش تلوریت هستند که باعث ایجاد کلنیهای سیاه میشود، در حالی که سایر استافیلوکوکها همیشه نمیتوانند این کار را انجام دهند.
- تریپتون، HM پپتون B و عصاره مخمر منابع نیتروژن، کربن، سولفور و ویتامینها هستند. سدیم پیروات نه تنها از سلولهای آسیب دیده محافظت میکند و به بهبودی آنها کمک میکند، بلکه رشد استافیلوکوکوس اورئوس را بدون از بین بردن انتخابی بودن محیط، تحریک میکند.
- لیتیوم کلرید و پتاسیم تلوریت رشد بیشتر میکروفلورهای آلودهکننده را به جز استافیلوکوکوس اورئوس، مهار میکنند.
- افزودنی تلوریت برای سویههای تجزیهکننده زرده تخم مرغ غیر از استافیلوکوکوس اورئوس سمی است و باعث سیاه شدن کلنیها میشود.
- گلیسین، پیرووات رشد استافیلوکوک را افزایش میدهد.
- با افزودن زرده تخم مرغ، محیط زرد و مات میشود. افزودنی زرده تخم مرغ، علاوه بر غنیسازی محیط، با آشکار کردن فعالیت لسیتیناز (واکنش زرده تخم مرغ) به فرآیند شناسایی کمک میکند.
- وجود یک ناحیه شفاف و همچنین کلنیهای خاکستری سیاه روی این محیط نشانه حضور استافیلوکوک کواگولاز مثبت است. پس از انکوباسیون بیشتر، یک ناحیه مات در اطراف کلنیها ایجاد میشود که میتواند به دلیل فعالیت لیپولیتیک (Lipolytic) باشد.

آمادهسازی و روش استفاده از برد پارکر آگار
- 63 گرم از آگار را در 950 میلیلیتر آب مقطر بریزید.
- محیط را حرارت داده تا به جوش آمده و محیط کاملا حل شود.
- با اتوکلاو کردن با فشار 15 پوند (121 درجه سانتیگراد) به مدت 15 دقیقه، محیط را استریل کنید.
- تا دمای 50 درجه سانتیگراد محیط را سرد کنید و 50 میلیلیتر امولسیون زرده تخم مرغ غلیظ و 3 میلیلیتر محلول پتاسیم تلوریت 3.5 درصد (FD047) یا 50 میلیلیتر امولسیون تلوریت زرده تخم مرغ (FD046) را به آن اضافه کنید.
- در صورت تمایل برای انتخابی شدن بیشتر، محتویات هیدراته شده 1 ویال مکمل BP Sulpha را اضافه کنید.
- به عنوان یک انتخاب دیگر، میتوان از یک ویال مکمل فیبرینوژن پلاسما (Fibrinogen Plasma) مهارکننده تریپسین (Trypsin) را به ازای هر 90 میلیلیتر از محیط به جای امولسیون تلوریت زرده تخم مرغ برای شناسایی کواگولاز، استافیلوکوک مثبت، استفاده کرد.
- محیط را خوب مخلوط کرده و در پلیتهای پتری استریل بریزید.
- قبل از استفاده، سطح پلیتهای آگار را برای یک دوره زمانی کوتاه خشک کنید.
- با یک اسپاتول (Spatula) شیشهای، مقدار 0.1 میلیلیتر از نمونه که در پپتون واتر (Peptone Water) بافر شده، رقیق شده را روی سطح آگار پخش کنید تا خشک شود. حداکثر 0.5 میلیلیتر میتواند در ظروف بزرگتر استفاده شود.
- ظروف را به صورت وارونه در دمای 35 درجه سانتیگراد انکوبه کنید.
- بعد از 24 ساعت ظروف را بررسی کنید و به دنبال کلنیهای معمولی استافیلوکوکوس اورئوس باشید.
- کشتهای منفی را برای 24 ساعت دیگر دوباره انکوبه کنید.
تفسیر نتیجه برد پارکر آگار
وجود کلنیهای سیاه، محدب و براق به قطر 1 تا 1.5 میلیمتر یک تست مثبت فرضی برای حضور استافیلوکوکوس اورئوس میباشد. کلنیهایی که رنگدانه سیاه ایجاد نمیکنند باید منفی تفسیر شوند.
| ارگانیسم | رشد |
| استافیلوکوکوس اورئوس | رنگ خاکستری-مشکی براق. ایجاد ناحیه مات در اطراف کلنی |
| پروتئوس میرابیلیس (Proteus mirabilis) | رنگ قهوهای-مشکی، فعالیت لسیتیناز منفی |
| میکروکوکوس لوتئوس (Micrococcus luteus) | سایههای قهوهای-مشکی (بسیار کوچک)، فعالیت لسیتیناز منفی |
| استافیلوکوکوس اپیدرمیدیس (Staphylococcus epidermidis) | رنگ سیاه، فعالیت لسیتیناز منفی |
| باسیلوس سوبتیلیس (Bacillus subtilis) | کلنی مات به رنگ قهوهای تیره، فعالیت لسیتیناز منفی |
| اشرشیا کلی (Escherichia coli) | کلنی به رنگ قهوهای مایل به سیاه بزرگ، فعالیت لسیتیناز منفی |
| استافیلوکوک ساپروفیتیکوس (Staphylococcus saprophyticus) | کلنی غیر معمول و ممکن است شفاف باشد. نواحی مات عریضی ممکن است در 24 ساعت تولید شوند |
| مخمرها | کلنی سفید رنگ، فعالیت لسیتیناز منفی |
موارد استفاده از برد پارکر آگار
- برای جداسازی و شمارش استافیلوکوکهای کواگولاز مثبت از مواد غذایی و نمونههای بالینی توصیه میشود.
- استفاده از برد پارکر آگار به طور رسمی توسط انجمن بینالمللی اداره شيميدانهاي تحليلي (AOAC) پذیرفته شد و توسط داروسازی ایالت متحده (USP) برای استفاده در انجام تستهای حد میکروبی توصیه میشود.
- کمیته ISO نیز این محیط را برای جداسازی و شمارش استافیلوکوک توصیه کرده است.
- برد پارکر آگار همچنین میتواند برای تشخیص فعالیت کواگولاز با افزودن فیبرینوژن پلاسما استفاده شود.
محدودیتهای برد پارکر آگار
- شناسایی استافیلوکوکوس اورئوس ایزوله شده روی برد پارکر آگار باید با واکنش کواگولاز تایید شود.
- اگرچه این محیط برای تشخیص کواگولاز مثبت استافیلوکوکوس اورئوس توصیه شده، اما باکتریهای دیگر نیز ممکن است در این محیط رشد کنند.
- علاوه بر این، آزمایشات بیوشیمیایی باید برای تأیید شناسایی ارگانیسم انجام شود.
- کلنیهای برخی از ارگانیسمهای آلوده کننده که در مجاورت کلنیهای کواگولاز مثبت رشد میکنند، ممکن است تا حدی واکنش هاله کواگولاز را هضم کنند.
جهت خرید و یا استعلام قیمت با ما تماس بگیرید یا در واتسپ پیام بزارید
مطالب مرتبط:
- اشدون آگار (Ashdown’s Agar): ترکیب، اصول، آمادهسازی، نتایج و کاربرد
- بروسلا آگار (Brucella Agar): ترکیب، اصول، روش آمادهسازی، نتایج و کاربرد
- مانیتول سالت آگار (محیط کشت MSA): ترکیبات، کاربرد، تهیه
- آگار ستریماید (Cetrimide Agar): ترکیب، اساس، کاربردها، آماده سازی و مورفولوژی کلنی
مترجم: صادق حسینیکیا





آیا درصورتی ک در تهیه امولوسیون زرده تخم مرغ مقداری سفیده همراه ان بلشد مانع تشکیل هاله شفاف اطراف کلنی میشود
بله،
وجود سفیده تخممرغ در امولسیون زرده میتواند مانع تشکیل هاله شفاف اطراف کلنی شود، چون سفیده حاوی آلبومین است که ممکن است بر فعالیت آنزیمی لیسیتیناز اثر بگذارد و نتیجه تست را مختل کند.